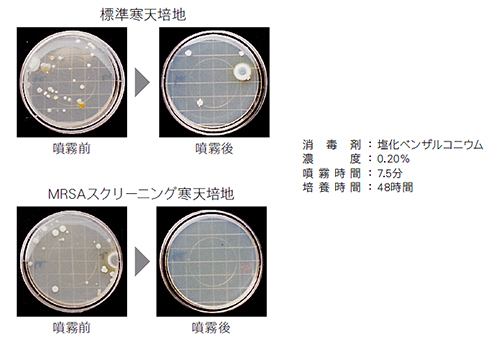

|
|
■包装資材 ■包装機械 ■物流機器 ■測定機器 ■洗剤 ■ケミカル ■蛍光灯 ■季節品-夏 ■季節品-冬 ■弱電工具 ■ホイスト ■環境機器 ■掃除機 ■ムーブテック ■切削工具 ■機械工具■調理厨房機器 ■研究室用品 ■安全防犯防災品 ■エクステリア ■新商品 ■在庫処分
| 背負い充電式消臭除菌噴霧機/ 品番 M885RF-HG | 【詳細表示】 | |||||||||||||
| 商品番号 | M885RF-HG | 価 格 | ||||||||||||

|
濡れない霧で空間ごと除菌。 面倒な設定は一切不要、スイッチ1つで誰でも簡単に操作可能で、あらゆる場所を濡らさず、精密に除菌・消臭できます。 |
背負い充電式消臭除菌噴霧機 |
||||||||||||
| ■特長 ●隠れた最近訳注浮遊菌まで除菌・消臭。人や物を濡らさないから乾燥時間が不要。  ●高所、床、あい路部のモニタリングを実施し、高い除菌効果が実証されています。 効果はアメリカで発表済みです。(Evaluation of an Automatic Disinfecttion Unit. (Environmental Health and Prevention Medichione Vol.6, No.3 October 2001)) ●肩や腰にかかる荷重を分散し、長時間作業のストレスを軽減。細部まで「使いやすさ」にこだわって設計しました。  ■使用例  ●背負い充電式消臭除菌噴霧機の件で 薬材に次亜塩素酸の薄め液は使用できますか? 次亜塩素酸水の希釈液を噴霧するのは、可能です。 但し、使用後は、DFHに内蔵されている、タンクを水道水 で洗うことをお勧めします。腐食性がありますので、その点 注意下さい。 ■仕様
| ||||||||||||||
運賃、および消費税は、記載価格には、含まれていません。

[トップページに戻る] [注文書] [見積り依頼] TEL 0729-64-8663 FAX 0729-61-4874
営業時間 AM9:00~PM7:00 営業日 月曜日~金曜日 定休日 土曜日 日曜日 祝日